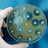
Antibiotika: Erstmals wieder über Pandemie-Niveau

Antibiotika: Da waren‘s nur noch zwei
Wegen der wiederkehrenden Engpässe bei Antibiotika wurden die Rabattverträge für diese Wirkstoffe vor zwei Jahren gelockert: Für Präparate, die zumindest teilweise in der EU produziert werden, muss bei den Ausschreibungen ein separates Los vorgesehen werden. Nach mehreren Runden steht fest: Die Regelung nach dem Engpassgesetz (ALBVVG) führt dazu, dass nicht mehr, sondern weniger Hersteller zum Zuge kommen.
„Zur Vermeidung von Lieferengpässen und zur Sicherstellung einer diversifizierten, bedarfsgerechten Versorgung“ müssen die Krankenkassen bei patentfreien Antibiotika mindestens die Hälfte der Lose für Wirkstoffe aus EU/EWR-Produktion ausschreiben, so sieht es die Regelung nach ALBVVG vor, die in § 130a Absatz 8a Sozialgesetzbuch (SGB V) übernommen wurde. Kommt dabei ein Übereinkommen mit einem Drittstaat über das öffentliche Beschaffungswesen zum Tragen, genügt es, wenn innerhalb der EU-Lose mindestens die Hälfte der zur Erfüllung der Vereinbarung benötigten Wirkstoffe in der EU/EWR produziert werden.
Die übrigen Lose können die Krankenkassen beziehungsweise ihre Verbände regulär ausschreiben, wobei hier Vereinbarungen mit mehr als einem Hersteller geschlossen werden müssen. Ziel ist es, dass auf die Zuschläge für EU-Produktion dieselbe Liefermenge entfällt wie auf die anderen Lose.
Allerdings gilt hier die Klausel: Gehen in einer der beiden Gruppen keine oder keine zuschlagsfähigen Angebote ein, hat dies „keinen Einfluss auf die Erteilung des Zuschlags in den anderen [...] ausgeschriebenen Losen“. Heißt: Kommt kein Vertrag für einen EU-Produzenten zustande, bleibt es bei den erteilten Zuschlägen für Anbieter mit Wirkstoffen aus Drittländern.
EU-Produktion als Ausnahme
Genauso ist es bei Ausschreibungen gekommen. Denn wie zuletzt die Zuschläge von AOK und GWQ zeigten, gibt es bei vielen Antibiotika gar keine EU-Produktion mehr. Beispiele sind Cefpodoxim, Cefuroxim, Ciprofloxacin, Clarithromycin, Clindamycin, Doxycyclin, Levofloxacin, Metronidazol, Moxifloxacin und Vancomycin.
Im Ergebnis blieben bei der AOK acht von 15 Wirkstoffen ohne EU-Zuschlag, bei GWQ konnten nur bei drei von elf Molekülen entsprechende EU-Lose vergeben werden. Die Folge: Weil ein Los wegfällt, gibt es statt bislang drei nur noch zwei Rabattpartner.
Zwei statt drei Rabattpartner
Beispiel Cefpodoxim: Hier können derzeit an AOK-Versicherte die Präparate von Ratiopharm, Stada und 1A Pharma abgegeben werden, ab Juni sind es nur noch Basics und Hexal. Beispiel Clindamycin: Statt Aristo, CNP und Hexal sind nur noch die beiden letzteren Hersteller an Bord. Einen EU-Partner gibt es nicht, das dritte Los ist damit verfallen. Bei Levofloxacin waren es bislang HEC, Heumann und Aurobindo, künftig sind es nur noch HEC und Hexal. Und bei Moxifloxacin bleiben Micro Labs und Holsten übrig; Heumann als bislang dritter Rabattpartner muss das Feld räumen.
Noch schlimmer sieht es bei Doxycyclin aus; hier gibt es bei GWQ ebenfalls keinen EU-Zuschlag und nur noch Hexal als Anbieter. Bei der letzten Rabattrunde waren mit Hexal und Aliud immerhin zwei Firmen an Bord.
Nach wie vor Engpässe
Die Entwicklung, nur noch zwei statt drei Rabattpartner an Bord zu nehmen, ist auch deswegen gefährlich, weil für die betroffenen Wirkstoffe nach wie vor Engpässe bestehen. So sind in der Datenbank des Bundesinstituts für Arzneimittel und Medizinprodukte (BfArM) derzeit Einträge zu Amoxicillin, Azithromycin, Ciprofloxacin, Clindamycin, Fosfomycin, Linezolid, Moxifloxacin, Ofloxacin, Phenoxymethylpenicillin und Vancomycin zu finden – also zehn der 17 zuletzt ausgeschriebenen Wirkstoffe.
Kritik an „Lex Hexal“
Ohnehin fällt auf, dass bei den EU-Losen fast nur Hexal und Teva zum Zuge gekommen sind, bei Linezolid ist es TAD, bei Ofloxacin Pharma Stulln beziehungsweise Dr. Winzer. Von der Konkurrenz wird das ALBVVG deshalb auch spöttisch als „Lex Hexal“ bezeichnet; der Konzern hatte gegen den Trend im österreichischen Kundl in eine Produktionsanlage für Penicilline investiert.
Führt das Gesetz wenigstens auf lange Sicht zu einem Umdenken und einer Wiederansiedlung in Europa? „Vergessen Sie es“, sagt ein führender Generikamanager. „Kein CEO wird deswegen ernsthaft über ein Werk in der EU nachdenken.“
lesen Sie weiter.